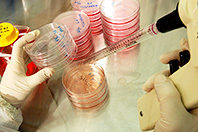
Ученые создали уникальные имплантаты для пересадки костного мозга

Медики напомнили о мерах профилактики летней ангины
Жара — еще не повод расслабляться, ангиной и другими вирусными заболеваниями можно заболеть даже в разгаре лета. В медицине ангину называют острым тонзиллитом. Этот недуг является инфекционным и заболеть им можно в любое время года, но чаще всего с ним сталкиваются зимой и летом. Различают несколько видов ангины и это зависит от того, каким возбудителем…